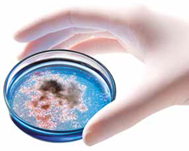

作者:ChristianBremer先生
工程碩士,Condair GmbH董事總經理
衛生加濕系統的規劃指南
前言:
衛生對于加濕的意義十分重要。VDI6022等現行法規對加濕的設計、規劃、制造和系統運行提出了很多要求。一方面,加濕對于建筑物的空氣調節必不可少,而另一方面,微生物在其中的作用舉足輕重。規劃指南應當在闡明衛生加濕設備要求的同時,并列出關鍵性的規劃準則。
1、石器時代與現代的空氣調節
回溯早期建筑,我們就會發現人類在很早的時候就已經開始利用空調系統。在學會建造棚屋和房舍之前,人類蝸居在洞穴中遮風避雨。這類居所并不是非常舒適。但只要在洞穴入口點起篝火,洞穴內的居民就可以避免遭受野獸傷害,并且還可以勉強用來驅寒。這就是人類最早的室內空氣采暖系統和空氣幕門。盡管當時像德國爐具條例之類的法規尚未問世,但仍然需要確保燃燒空氣能夠充分流動以及生活區最起碼的煙氣排放。
當然,那個時候新鮮空氣顯然足夠充分,因此不需要進行額外的送風。而對于工作環境空氣當時也沒有什么約束性要求。沒有什么26°規定,沒有反歧視法,但有沒有霸凌行為不得而知。
勞動者的精神壓力-當時應該都是自由職業者-通常主要來自于野獸或敵人。溫度、濕度和亮度這些物理參數只與天氣本身有關。這些參數關系是否適當取決于特定勞動地點的選擇,這些主要由勞動者自己決定。含有高濃度二氧化碳的污濁空氣或無法忍受的噪聲污染要么根本不存在,要么人們無所謂。
然而,對于人們長期居住其中的現代建筑,其特點主要在于具有厚厚的外墻,以及與室外空氣全然不同的室內空氣。室內氣溫全年保持穩定,僅存在很小范圍的波動。新鮮空氣由建筑物的通風和空調系統或其他設施提供,并能夠根據室外空氣條件和室內要求隨時生產。

過于干燥的室內空氣往往會造成呼吸道疾病,比如咳嗽、感冒、支氣管炎和鼻竇炎癥。
2、加濕需求
2.1 得當的空氣濕度所提供的舒適與健康保障
在寒冷的采暖季節,室內濕度可能會降到30%RH以下。長時間生活在這種干燥的室內空氣氛圍,人們往往會受到干燥問題困擾。
這主要是因為干燥的呼吸道粘膜無法迅速將灰塵、污垢和病原體攔截在呼吸道之外。在這種地方停留的時間越長,患呼吸道疾病的風險就越高。后果一般就是咳嗽、感冒、支氣管炎和鼻竇炎癥。
在急性疾病發病之前,過于干燥的室內空氣往往就已經產生很多次生體驗,比如室內氣氛不適,活力下降,感覺疲憊,眼睛感覺刺激或者喉嚨沙啞等等。
盡管人們對于氣溫非常敏感,但由于某些次生現象,過低的濕度會首先引起人們的注意。
感覺舒適和健康的最佳空氣溫度為21-22°C,相對濕度為40-60%之間。但是也要注意,室內溫度體驗會受到個人偏好影響,并沒有明顯的界限。感覺舒適的空氣濕度往往與室內空氣灰塵含量存在關聯。這種粉塵含量可能會受到設施選擇的影響,但在普通居住區顯然不會達到潔凈室的空氣質量。因此,采暖期的充分加濕會改善室內空氣質量,有利于人類健康。

2.2 舒適空調的空氣濕度要求
就舒適區的最低空氣濕度要求而言,理論假設與實際體驗之間存在很大差異。但是很容易發現,一旦人們有了個人的舒適體驗,這些都僅僅是表面上的問題。空氣溫度和相對濕度的關系顯而易見。
非住宅建筑的通風DINEN13779:
“在常規室內空氣溫度20-26°C范圍內,如果相對濕度在30-70%之間,就幾乎不會存在不舒適的問題。”
一方面,這證明了溫度和相對濕度之間的關系;另一方面,相同的舒適體驗值都在規定值范圍內。

2.3 相對濕度的最低值——40%
德國建筑氣候研究所將舒適區的相對濕度下限設定為40%。根據各種經驗以及來自科學和職業醫學的綜合數據,該值在衛生,舒適性和生產率方面非常契合。
Scofield/Sterling圖:
Scofield/Sterling圖展示了在不同室內濕度水平下,可以保障舒適度及健康的正確相對濕度。有害微生物的滋生或是特殊病癥的發生風險,都會在40-60%這一相對濕度范圍內被降到最低,因此這是最理想的狀態值。
3、加濕方法
加濕可通過汽化、霧化和蒸發這三種物理方法實現。具體哪種方法效果最佳取決于相應的應用。但無論如何,從衛生角度看,這三種方法對加濕設備的選擇存在不同的要求。

蒸汽形式的等溫加濕
3.1 蒸汽類
首先,蒸汽加濕因其存在高溫過程而具備最高衛生安全性。但是,如果蒸汽分配器安排不當或加濕范圍測量不準確,可能也會出現問題。如果當前的加濕范圍過小,那么最好選擇多個蒸汽分配系統。由于系統空氣在均勻蒸汽分配過程中混合更迅速,因此會大幅度縮小加濕范圍。
霧化形式的等焓加濕
3.2 霧化類
從衛生角度來看,純霧化加濕器存在的問題最大。所需的加濕范圍可能變化很大。最重要的是濕度增加之后,霧化加濕水的空氣溫度、氣流速度、氣流剖面和氣溶膠大小。水氣溶膠的漂浮性、相關不良沉積的可能性及其緩慢蒸發讓加濕范圍的可靠計算變得異常困難。
生物膜的形成導致受微生物污染的加濕水無法完成吸入空氣的加濕霧化。不要讓水氣溶膠進入加濕系統下游的空氣管路,否則其可能會在那里沉積,并形成具有衛生危害性的潮濕表面。
蒸發形式的等焓加濕
3.3 蒸發(濕膜)類
蒸發(濕膜)加濕器的加濕范圍由設計決定。但是,必須確保膜體上形成的生物膜不會導致系統中的空氣受到微生物污染。

衛生準則之一——
4、加濕段長
4.1 測量加濕段
加濕段由霧化區以及后續的擴展區和混合區組成。霧化區是加濕系統的下游段——從蒸汽的釋放到通過系統空氣將其完全吸收;隨后為擴展區和混合區。所引入的潮濕空氣在此與氣流均勻混合。加濕段長取決于沿氣流方向的后續組件構成。準確確定加濕段長對于防止風道內發生冷凝現象有著非常重要的作用。了解該距離對于正確的濕度控制也具有重要意義,這是因為控制傳感器只能安裝在具有均衡濕度值的位置。
4.2 蒸汽加濕的加濕段長
自動計算得出的蒸汽加濕段長無法達到足夠的精度。在狹窄空間中可設有多個蒸汽分配系統。由于通過大量注入蒸汽,系統空氣的混合能夠更快,這樣加濕段長就能顯著縮短。與此同時,蒸汽的均布要求還應與VDI6022中的表1相吻合。
4.3 等焓加濕的加濕段長
諸如雙次汽化加濕器或各種濕膜類加濕器的等焓加濕系統,其加濕段長是由設計確定的。確定高壓和超聲霧化類加濕器的加濕范圍要困難得多。最重要的一些變量包括濕度增加量、空氣溫度、風速、氣流剖面,以及尤其重要的霧粒大小。正是霧粒的不良沉積或蒸發緩慢讓加濕段長的確定變得非常困難,幾乎無法獲得可以讓我們進行有效評估的可靠信息。只有當等焓加濕系統沒有霧粒排出時,才能進行可靠的加濕段長計算。

衛生準則之二——
5、防止生物膜
5.1 生物膜的危害
加濕器供水的微生物質量應與飲用水相仿。因此,最多允許100CFU/ml。即使這種情況下,少量微生物也會沉積在水管、蒸發體或加濕器的潮濕區域,并且在一段時間之后形成大量的生物膜。生物膜經過幾天到幾個月的積累就可以達到其靜止期,此時將會難以被人發現。
從此時起,生物膜不斷釋放細菌,隨后加濕水或系統空氣受到不受控制的污染。
5.2 加濕過程的哪個階段會出現生物膜?
幾乎在所有被水潤濕的表面都可以沉積和繁殖具有衛生危害性的生物膜。風險較高的是:
- 與加濕器相連的供水管
- 加濕系統內部的水管
- 濕膜膜體
- 擋水板
- 儲水箱
- 加濕桶
5.3 加濕過程如何避免出現生物膜?
采取適當措施就可遏制或避免生物膜的形成。采取個別的措施并不能達到目的,只有結合所有衛生相關措施才能夠確保最終成功。以下方面特別重要:
藻類:
藻類是水中植物相關的單細胞或多細胞生物。加濕器特別容易受到綠藻和褐藻的侵襲。這些侵襲可能會造成人體的防御反應(發燒)或過敏。

真菌:
真菌通常會形成可見的菌落,或稱為菌花,即使在光滑表面上也可以廣泛傳播。
它們主要在潮濕區域或系統出氣處沉積,通常幾周之后開始釋放孢子。如果孢子進入人類的呼吸道,它們也會在那里形成菌落并引起霉菌感染。
細菌/病毒:
細菌會產生難聞的氣味,并且造成系統中的粘液積聚。軍團菌等桿狀細菌可引起致命的感染或傳播致病細菌,攻擊人體免疫系統。
病毒也會在空氣中傳播,沉淀在宿主細胞內或宿主細胞上,并通過后者細胞中的自身基因組破壞外來生物。衛生準則之三——
6、含水氣溶膠


6.1 含水氣溶膠的健康危害
空調內的氣溶膠通常會造成麻煩,因為它們常常會帶來健康危害,所以不能讓其進入通風管系統:
- 帶水氣溶膠可沉積在空氣管道中,并形成具有衛生性危害的潮濕表面;
- 在加濕用水受到微生物污染的情況下,細菌最終會在吸入空氣中與氣溶膠相結合;
-由于水氣溶膠的尺寸很小,很難或者有時根本無法分離。由于其通常具有漂浮性,能夠通過通風管道進行遠距離運輸,并且不會完全蒸發,最終可能進入吸入的空氣中。
6.2 水氣溶膠與生物膜的結合
根據其大小不同,吸入的水氣溶膠可以進入不同深度的呼吸道。被微生物污染的加濕水可以讓有害細菌深入呼吸道內部。因此,當存在生物膜積聚時,水氣溶膠必須被作為非常敏感的物質對待。
含水氣溶膠在呼吸道中的可滲透深度:
- 呼吸段(測量范圍0.5-18.5μm):鼻喉部位10-5μm 、氣管5-3μm;
- 胸部(通過喉部進入支氣管的氣溶膠):支氣管3-2μm、細支氣管2-1μm;
- 肺部(滲入肺泡的氣溶膠):肺泡1-0.1μm。
6.3 有關含水氣溶膠潛在危害的臨床知識
因吸入霧化加濕器受污染含水氣溶膠引起的外源性過敏性肺泡炎(EAA)多個病例已在臨床研究中得到證實。外源性過敏性肺泡炎(EAA)主要由有機粉塵、霉菌、酵母和細菌引起,癥狀表現為咳嗽和呼吸短促的發燒。其可能會對體弱者造成生命危險。
6.4 含水氣溶膠在VDI6022表1中的處理
加濕器的設計和操作必須符合VDI6022表1要求,以確保含水氣溶膠不會最終進入風道系統。
6.5 含水氣溶膠分離的可能性
通常水霧分離器在將小尺寸含水氣溶膠與氣流分離時,表現無能為力。由于質量輕,其很容易適應氣流方向的變化,因此無法通過離心力的作用分離。但無論如何,生物膜可以在所有分離器裝置內部產生,因此始終存在潛在的危險。
典型的水霧分離器圖:霧滴直徑低于極限霧滴尺寸的含水氣溶膠無法分離。它們能夠穿過分離器并滲透到系統空氣或吸入空氣中。無論如何,第6.2節所述的呼吸道有害含水氣溶膠都會因為尺寸過小而不會受到阻擋。

衛生準則之四——
7、濕度控制
7.1 衛生加濕的控制概念
從衛生角度來看,加濕系統的適當控制非常重要。必須避免在正在運行的系統無法達到露點,而且空氣管道系統不應存在冷凝物沉積。但不管怎樣,空氣加濕總歸是水變化為蒸汽的物質狀態變化。不當的控制概念也會導致這種物質狀態變化發生逆轉。h,x圖展示了各種加濕方法的不同熱力學過程。鑒于這些過程存在差別,我們一開始就可以確定不存在加濕器控制的通用解決方案。
7.2 蒸汽加濕器的控制
蒸汽加濕是一個近似等溫的過程。加濕過程中僅有極其細微的空氣溫度升高。為此,在濕度控制中通常只會考慮系統或室內空氣的濕度值。
7.3 等焓加濕器的控制
控制策略推薦表:
等溫
√√
√
-
-
-
等焓-連續可調
--
-
-
√
√
等焓-不連續可調
--
-
√
-
-
衛生準則之五——
8、衛生性證據

可靠的衛生證據應當涵蓋所有衛生相關問題,其中包括長期的微生物穩定性、預防性衛生措施以及以衛生為導向的維護概念。
8.1 長期的微生物測量、衛生證書和類型試驗
評估加濕系統的衛生證據有很多種,加濕系統通常應當能夠實現技術和衛生角度的多年無故障運行。
作為入口物質,吸入的空氣還應滿足食品衛生要求。除遵守技術標準和相關法律法規外,個人衛生要求也起著重要作用。根據經驗,其對吸入空氣的要求特別高。
僅通過特定指導確認設備和部件技術和結構合規性的型式試驗并不構成衛生方面的證據。衛生安全的一個重要前提是,所有與微生物和衛生相關的要求均已得到充分的考慮和評估。
其中還應包括遏制病菌生長的預防措施,以及基于現有知識的維護和維修活動。因此,只有在涵蓋并滿足所有必備衛生屬性時,才有可能對加濕系統的衛生質量進行評估:- 遵守技術準則
- 減少微生物的有效衛生措施
- 定期清潔和消毒
9、五項衛生準則
為了確保衛生加濕,必須避免加濕器中出現細菌積聚以及細菌進入系統空氣或吸入空氣。
無論使用何種加濕方法,均必須始終滿足上述5個衛生標準。
在決定采用特殊加濕設備時,建議對擬定的設備技術和衛生措施進行認真審查。最后,可參考可靠的衛生證據評估加濕系統的衛生操作。
10、參考文獻
[1] DINEN13779-非住宅建筑的通風[2] “飲用水條例”
[3] VDI6022表1-通風和空調系統和設備的衛生要求
[4] Recknagel-Sprenger-Schramek:暖通+空調手冊07/08
[5] 德國建筑氣候研究所:有關室內空氣濕度的問題和解答,FGK狀態報告8
[6] 德國建筑氣候研究所:40%為相對濕度的下限值,FGK報告407
[7] 巴伐利亞州環境和消費者保護部:采用霧化設備的加濕器引起肺部疾病的疑似性,新聞稿第445號
[8] BG職業安全與健康研究所,氣候和空氣質量中心,第0195號信息
[9] Keune, A.:聲明與隱秘之間的健康空氣,CCI Print 07/2003
[10] Hüster, R.:衛生和設備領域的現代加濕,VDI報告1921(2006)
[11] Grandjean, E.:濕度中的生物學觀點,蘇黎世聯邦理工學院
[12] Baron, P.:空氣顆粒物(氣溶膠)的產生與行為,氣溶膠101(國家職業安全與衛生研究所,美國)
[13] Steiner, R.:等焓加濕的理論與實踐,TAB10/2006
[14] Steiner, R.:加濕——等焓或者使用蒸汽,TAB03/2007
[15] Bremer, C.:加濕的規劃指南標準:關于控制,沃特美爾(氣候德國)公司,12/2007(第3版)









